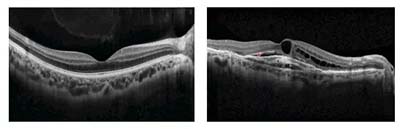
微信图片_20230118101712.jpg

专家谈健康
看不清楚东西,而且还是弯曲的 我眼睛里长了个“黄斑”?
这个“黄斑”到底是啥?
人眼的结构就像传统相机一样,大致由镜头和底片组成,镜头的作用是透明和聚焦,底片的作用是成像。眼睛内部的视网膜(又叫眼底)就是成像的底片。而在这个视网膜的中心有一块小范围的区域,有着非常密集的感光细胞,这些细胞可以接受光线的刺激,对于我们的视力形成来说是最重要的、最敏锐的部分,我们把这片区域命名为黄斑。出现视物模糊或者视物弯曲等情况并不是因为长了黄斑,而是黄斑出现了病变。

黄斑疾病多发生于老年人,有年龄相关性黄斑变性、黄斑裂孔、黄斑前膜、玻璃体黄斑牵引等。今天向大家详细介绍一下年龄相关性黄斑变性。
为什么我越想看哪儿,却越看不清楚?

正常人眼中的物体(左)和黄斑变性患者眼中的物体(右)
黄斑是我们的视觉中心,黄斑病变一般会引起中心视力的异常。常见表现是正前方视力的明显下降、视物变形或伴有色觉改变,可以说“越想看清哪儿,越看不清楚”,而周边的物体看起来则是正常的。
这到底是一个怎样的疾病呢?
年龄相关性黄斑变性,通常被简称为AMD。这个群体占普通人群的比例越来越大,可以说,黄斑变性造成的视力下降是一个日益严重的问题。
在我国,AMD是50岁以上人群的主要致盲原因,其患病率随年龄增长而增高。
AMD分为两种类型:

1.干性AMD:对视力的影响较小,患者自觉症状比较轻,视力下降的幅度较低,往往没有视物变形;
2.湿性AMD:往往视力会急剧地下降,出现视物变形,进行眼底检查时,可以看到黄斑正常结构被破坏,出现了水肿、新生的血管,甚至是出血。
美国眼科协会相关指南指出:在AMD患者中,虽然干性AMD比例达到80%,但AMD造成的90%的严重中心视力丧失均由湿性AMD引起。
怎么能早期发现AMD?
1. Amsler's 检查
Amsler方格表是一个非常敏感的测试,它可以让您尽早发现中央视力的问题,甚至先于医生的检查。
它的使用方法也非常简单:
①找一处光线清晰平均的地方,把表格放在视平线30cm的距离处进行观察;
② 如果有老花或近视的人佩戴原有眼镜进行测试;
③ 用手遮住左眼,只用右眼看,再交替进行;
④ 每周、每月做一次,可能会发现平常双眼视物时所不易发现的黄斑病变。

正常的Amsler方格(左1)和黄斑变性患者看到的Amsler方格(右3)
如果在测试过程中,发生了由视物正常(图示左1)变为了中心出现暗点、变形或缺损的情况(图示右2-4),提示您的黄斑很有可能出现了病变,建议进一步到医院排查。
2. OCT检查
OCT检查是目前AMD最常用的非侵入性的诊断手段,通过视网膜下液体的吸收和渗漏情况来指导治疗。
OCT结果显示
正常的黄斑形态如上图左1所示,为中央凹陷,两侧层次分明的类似“驼峰”的形态;而AMD患者的黄斑如上图右1所示,中央出现了严重的水肿,而且层次被破坏。
3. 眼底荧光造影
眼底荧光造影是目前AMD最常用的侵入性的诊断手段,它可以形象地显示出黄斑区病变的位置及病变的严重情况。
AMD如何治疗?
1. 预防危险因素
吸烟是AMD发病的危险因素,因此要戒烟;绿叶菜中含有大量的维生素和叶黄素,可以营养黄斑;日常服用一些抗氧化剂,同时注重控制体重和血压。
2. 干性AMD如何治疗?
干性AMD尚无明确有效的治疗方法,可以通过健康饮食、运动、减少紫外光线辐射(佩戴太阳眼镜)进行预防。同时,口服叶黄素(>10mg/天)、玉米黄素。叶黄素又名“植物黄体素”,是一种类胡萝卜素,可以保护视网膜和黄斑。
3. 湿性AMD如何治疗?
目前公认的有以下几种治疗方法:
1)抗VEGF(新生血管生长因子)眼内注射;
2)光动力治疗;
3)激光光凝;
4)手术治疗。
其中,抗VEGF(新生血管生长因子)眼内注射是湿性AMD的一线治疗方案,是目前临床上普遍应用的治疗方案。
年龄相关性黄斑变性是眼科老年人群中常见、且治疗相对棘手的一类疾病。
“早发现、早治疗”能维持较好的视力;若等到视力下降明显或持续时间较长再来就诊,黄斑结构被破坏的程度较大时,治疗后的视力往往不佳。
作者介绍

周怀蔚
北京老年医院眼科
医学硕士,2020年毕业于天津医科大学。主要从事眼科眼底疾病诊断与治疗。发表第一作者文章1篇,SCI收录文章2篇。
